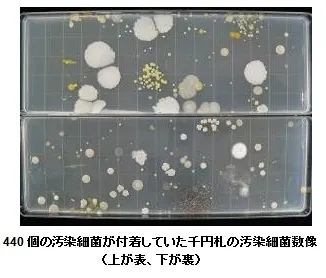
440個の汚染細菌が付着していた千円札の汚染細菌数像

現金の清潔度調査を実施 ~日常的に使用する紙幣と硬貨の汚染細菌付着実態が判明~
調査・報告
2013年6月19日 15:00各種工業製品や環境の汚染微生物について調査研究している衛生微生物研究センター(所在地:東京都葛飾区、所長:李 憲俊)は、2013年5月、東京23区内の飲食店ならびに物販店で採取した紙幣と硬貨を対象に、汚染細菌の付着状況を把握する調査を実施いたしましたので、その結果をここに公表します。
今回の調査では、実際に市中に出回っている現金の汚染実態を把握することを目的に、調査員が東京23区内の10か所の店舗において買い物を行い、紙幣と硬貨をお釣りとして収集しました。その上で、日常的な買い物によく使用されると考えられる千円札、百円玉、十円玉を選定し、また汚染細菌が付着しやすい形状だと想定される穴あき硬貨として五十円玉を加えて、合計4種類をそれぞれ10枚ずつ検体として用いました。汚染細菌数の測定は、紙幣は両面をそれぞれ専用の培地に押し付けて培養し、培養後の汚染細菌の集落をカウントしました。また、硬貨は滅菌水で洗い出した液を希釈培養する方法を用いました。
調査の結果、10枚全ての千円札には、多くの汚染細菌が付着していることが確認されました。お札一枚当たりの付着量は、最少で62個、最大で440個となり、同じ千円札でも付着量に開きがあることが明らかになりました。一方、硬貨における調査では、五十円と百円玉に一定量の汚染細菌が付着していることが確認されましたが、付着量はそれぞれ、平均13個、6個と、千円札を大きく下回りました。さらに、十円玉は検出限度以下であり、汚染細菌は培養されませんでした。
また、検出された汚染細菌の種類についてさらに調査を進めた結果、千円札2枚からは、厚生労働省から主な食中毒病因物質として指定されているセレウス菌(Bacillus cereus)が検出されました。
■セレウス菌とは
セレウス菌は、厚生労働省により、腸管出血性大腸菌やサルモネラ菌、黄色ブドウ球菌などに並ぶ「細菌性の食中毒病因物質」として指定されている。
厚生労働省ホームページ: http://www.mhlw.go.jp/topics/syokuchu/03-link.html
<特徴>土壌などの自然界に広く生息する。毒素を生成する。芽胞は90℃、60分の加熱でも死滅せず、家庭用消毒薬も無効。
<症状>嘔吐型と下痢型がある。
嘔吐型:潜伏期は30分~6時間。吐き気、嘔吐が主症状。
下痢型:潜伏期は8~16時間。下痢、腹痛が主症状。
食品安全委員会ホームページ: http://www.fsc.go.jp/sonota/b.cereus.pdf
http://www.fsc.go.jp/sonota/factsheets/06bacillus_cereus.pdf
衛生微生物研究センター所長の李 憲俊(リ ノリトシ)は、今回の調査結果について次のように述べています。
「日常的に不特定多数の人と頻繁に交換が行われる現金について、汚染細菌の付着状況を本格的に把握し、清潔度を調査した国内の事例は、これまでに殆どありません。今回、実際に市中に出回っている現金を対象に汚染細菌の付着状況を調査したことにより、特に紙幣において、硬貨より多くの汚染細菌が付着していることが確認されました。また、紙幣には、健康に害を及ぼすセレウス菌が付着していることも明らかになりました。今回の調査結果が、人々が健康的に生活するための一助となれば幸いです。」
【調査実施概要】
調査内容 紙幣と硬貨の汚染細菌数、ならびに汚染細菌種類を調査
■調査時期 2013年5月
■検体 千円札、百円玉、五十円玉、十円玉、各10枚
■検体採取場所 東京23区内の飲食店、物販店10か所
■調査方法
紙幣:店舗より受け取った紙幣を普通寒天培地にスタンプし、35℃、48時間培養。
その後に形成された集落数をカウントして、汚染細菌数を測定。
さらに、黄色ブドウ球菌とセレウス菌の有無について調査。
貨幣:店舗より受け取った硬貨を減菌プラスチックボトルに収集し、希釈培養法を用いて汚染細菌数を測定。
※本調査結果について引用や転載をする場合には、「衛生微生物研究センターによる調査」である旨を明示してください。